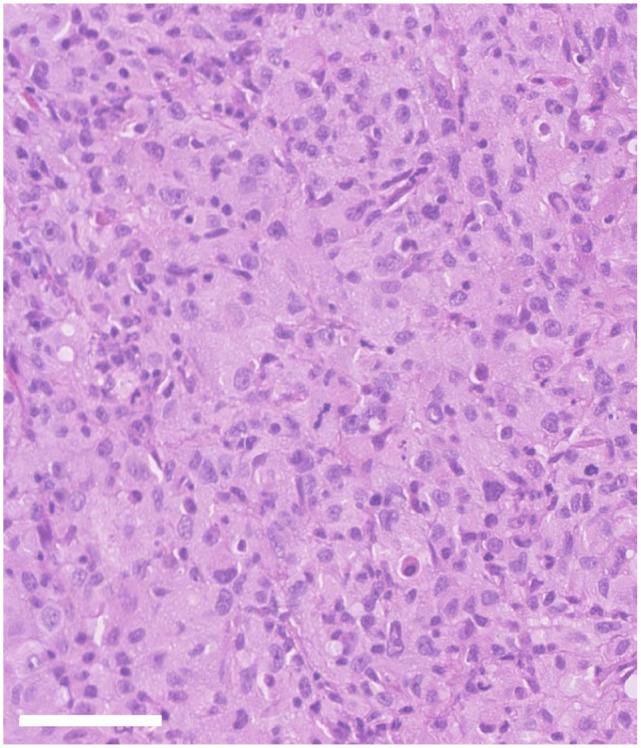
https://cdn.ncbi.nlm.nih.gov/pmc/blobs/00f1/7682218/0ce6cdd8d22a/10.1177_2055116920971248-fig1.jpg

猫口腔组织细胞肉瘤
Oral histiocytic sarcoma in a cat.
作者信息
Néčová Slavomίra, North Susan, Cahalan Stephen, Das Smita
机构信息
Southfields Veterinary Specialists (formerly VRCC Veterinary referrals), Laindon, UK.
Synlab VPG/Histology Ltd, Bristol, UK.
出版信息
JFMS Open Rep. 2020 Nov 19;6(2):2055116920971248. doi: 10.1177/2055116920971248. eCollection 2020 Jul-Dec.
CASE SUMMARY
A 15-year-old neutered male domestic shorthair cat presented with a 4-week history of dysphonia and reluctance to chew hard food. Oral examination revealed a mass lesion on the caudal soft palate. Biopsy was performed and histopathology with immunohistochemistry was most consistent with histiocytic sarcoma. CT of the head identified a discrete, left-sided, soft tissue mass lesion cranial to the tonsil with bilaterally symmetrical regional lymph nodes. CT of the thorax was unremarkable. Surgical removal achieved cytoreduction but not complete removal. Adjuvant chemotherapy with lomustine 10 mg (30 mg/m) was initiated. The patient developed suspected pancreatitis 2-3 weeks postoperatively, so further chemotherapy treatment was discontinued, but supportive treatment with pain relief and appetite stimulants was provided. Three months postoperatively, the patient developed recurrent dysphonia, and oral examination revealed a suspicion of local recurrence. Confirmation of diagnosis (cytopathology or histopathology) was not obtained. Supportive treatment to maintain a good quality of life was continued and the patient was euthanased 6 months after diagnosis owing to progressive disease.
RELEVANCE AND NOVEL INFORMATION
Only a few reports have been published describing histiocytic diseases of cats. To our knowledge, this is the first report of a feline histiocytic sarcoma of the oral cavity. Therefore, histiocytic sarcoma should be considered as a differential diagnosis in feline patients with an oral mass, especially if histopathology suggests a pleomorphic and poorly differentiated sarcoma. Immunohistochemistry for the confirmation of cell line origin would be strongly recommended.
病例摘要
一只15岁已绝育的雄性家猫出现了4周的声音嘶哑和不愿咀嚼硬食物的症状。口腔检查发现软腭尾部有一个肿块病变。进行了活检,组织病理学和免疫组织化学检查结果最符合组织细胞肉瘤。头部CT显示扁桃体上方有一个离散的左侧软组织肿块病变,伴有双侧对称的区域淋巴结。胸部CT检查无异常。手术切除实现了肿瘤细胞减灭,但未完全切除。开始使用洛莫司汀10毫克(30毫克/平方米)进行辅助化疗。患者术后2 - 3周出现疑似胰腺炎,因此停止了进一步的化疗,但给予了止痛和食欲刺激剂的支持性治疗。术后三个月,患者再次出现声音嘶哑,口腔检查怀疑有局部复发。未获得确诊(细胞病理学或组织病理学)。继续进行维持良好生活质量的支持性治疗,患者在诊断后6个月因病情进展而实施安乐死。
相关性和新信息
仅有少数关于猫组织细胞疾病的报道发表。据我们所知,这是首例猫口腔组织细胞肉瘤的报告。因此,对于患有口腔肿块的猫科动物患者,应将组织细胞肉瘤视为鉴别诊断之一,特别是当组织病理学提示为多形性和低分化肉瘤时。强烈建议进行免疫组织化学检查以确认细胞系起源。